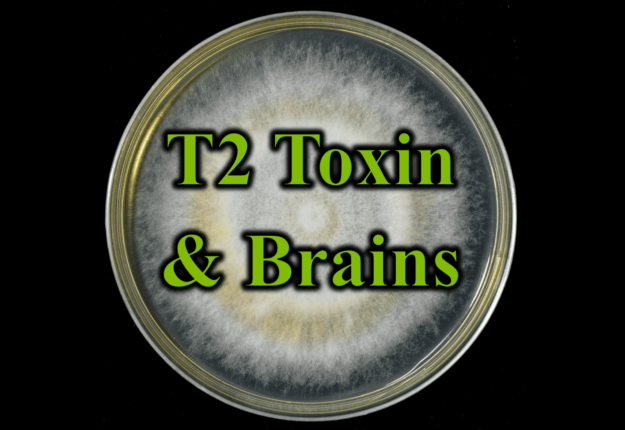

Autoimmune Form of Schizophrenia
As researchers search for the yet to be discovered mechanism behind schizophrenia, they have traced some cases of this psychiatric condition back to an autoimmune connection- at least in mice. As with many neuropsychiatric diseases, multiple different triggers can lead to similar symptomatic pictures for the person afflicted. The search for answers and therapies requires…